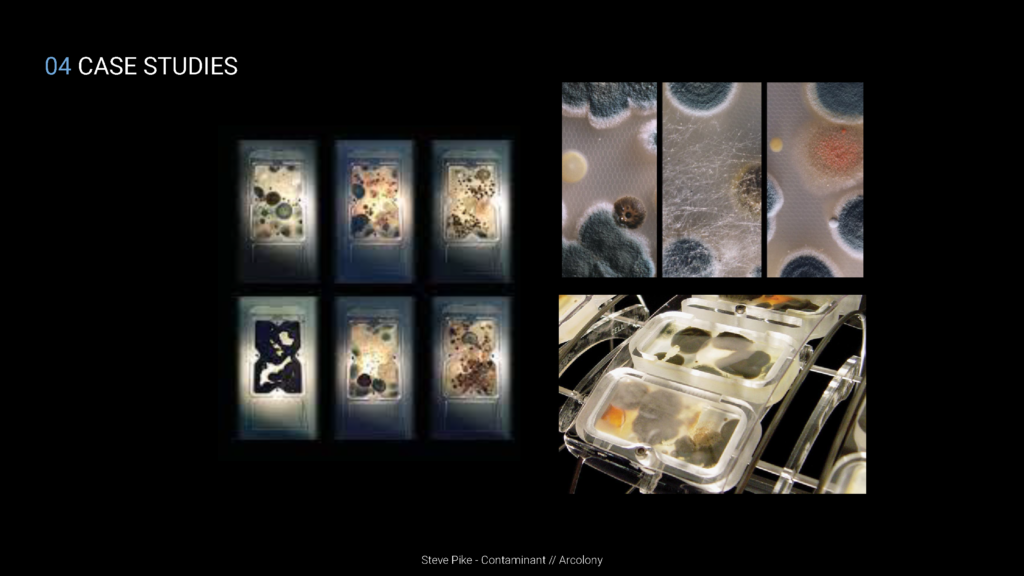

Diller Scofidio + Renfro, Blur Building, 2002, via twitter.com/y2k_aesthetic/status/1121933492781109248/photo/1
Air has many connotations in spirituality, mysticism, comfort, and as a medium in science. It has the ability to invoke the feeling of being in the present moment through the stimulation of senses, similar to feelings of pleasure, or on the other end of the spectrum, pain.

Mind Map Diagram
Air as a medium has the ability to create associations that emotions can have with a sense of place. For example, Pliny the Younger’s description in “The Dynamics of Sensual Atmospheres” by Malte Wagenfeld about his villa, painted in the image of the qualities of space while keeping the architecture as contextual information, is an attestation to the fact that these associations can be programmed to invoke deep psychosomatic experiences and connections. What Malte Wagenfeld ultimately concludes in his paper is that designing with both the phenomenological feelings, while being mindful of the technical performance of aspects such as comfort, would be the ideal scenario of creating meaningful architectural spaces[1].

Top Left: Malte Wagenfeld, Vortex Formations, 2008; Top Middle: Malte Wagenfeld, Capillary Waves on water’s surface, 2006; Top Right in order: Malte Wagenfeld, Laser luminesced atmosphere, 2007; Malte Wagenfeld, J. Parmington, P. Watkins, R. Ayyar and I. de Gruchy, Laser-light and fog to observe a woman’s breath, 2007; Malte Wagenfeld, J. Parmington, P. Watkins, Heat Convection from a fingertip, 2008; Malte Wagenfeld, Multiple scanning lasers to visualize air through several planes, 2008; Bottom L to R: Atmospheric Sensitivity, Aesthetics of Air, RMIT Gallery, Connection between outside weather and it’s effect on the fog inside the gallery through varying conditions, April – May 2011. All images via The Dynamics of Sensual Atmospheres in Dynamics of Air, 2013.
Another aspect that can be drawn from Malte’s writing in “The Dynamics of Sensual Atmospheres,” is the quality of air as a medium constantly in flux[1]. With that said, air is not the only medium being used. While it is the overarching theme, it is still being induced, activated, mixed in, and mutated using other mediums that also have a resulting sensory perception. Examples are smell, sight, sounds, feelings of space, perceptions of memories and spatio-temporal connections to familiarities, thereby inducing a spiritual existence of being in the present moment. Air is like water, it gets mixed in with other liquids or colours, and it takes on that shape. Just like water, air is also a fluid, the medium is the same and the state is different due to the temperature it would take to bring water to the same state. Therefore, again, an external stimuli like heat is required to do so. Thereby reaffirming that the fluid requires another agent to be activated.

Top L to R: Edith Kollath, Liminal Passage, 2018; Bottom Left: Breathe Earth Collective, Aerosol, 2018; Bottom Middle: Helen Dilkes, Fluidifying… exploding body, event in the making, 2018; Bottom Right: Little Wonder, 10 kinds of Fog, 2018. All images via Dynamics of Air. RMIT Gallery, 2018.
Among the exhibits in Dynamics of Air at the RMIT gallery curated by Malte Wagenfeld and Jane Burry, many samples of how air can be activated are demonstrated. For example, in Edith Kollath’s Liminal Passage, an embodiment of air in sight, smell, and a deep association with another human being comes into being[2]. Through the sharing of a breath, passed through water, with a complete stranger, an intimate relationship is suddenly created. While this happens every day anytime someone passes another person on the street, or through presence in the same room, it never makes us realize that we are constantly breathing the same air that has passed through someone else’s body. Once this realization is had, the epiphany it creates is that we are all inside each other. This would not be possible unless the air is activated through an apparatus thereby invoking this spiritual and physiological ideal[2].

Top Left: Alien Prometheus, Opening Scene, 2012, via www.alien-covenant.com/topic/49192; Top Right: Blade Runner 2049, Water Reflection Effect, 2017, via www.rogerdeakins.com/lighting-2/water-reflection-effect/; Bottom Left: Pyramus and Thisbe, Set and Lighting Design, 2013, via pin.it/3uJOkgk; Bottom Right: Tron Legacy, Atmosphere and Lighting Cityscape, 2010, via www.wallpaperflare.com/city-artwork-fantasy-art-tron-futuristic-movies-tron-legacy-wallpaper-uryui
As we begin to understand how to evoke similar underlying psychosomatic connotations, we begin to find a deeper meaning with our association to “place” in architecture. This idea led the research to take a direction into catalogues or archival information where we may find precedents or ideas to extract from. According to Amir Soltani in his writing “Atmospheric Gestures of Architecture in Cinematic Aided Design Framework,” one of the most untapped banks of such information can be found in cinema and the effects that are choreographed in order to evoke emotions in the audience[3]. If through the projection of images, colour, environment, wind, shadow, and conflict (sweat, haze, fog), even someone in the audience can feel an empathic connection to the desired effect, then it is one of the indicators that the filmmakers have succeeded in their endeavour. While this relates to the many atmospheric stimuli that can be activated, if we apply it to air as the central medium, we begin to find similar opportunities such as those experimented with in the “Dynamics of Air” exhibit curated by Malte Wagenfeld and Jane burry[2].
The idea of thinking in phenomena, as laid out by Malte Wagenfeld in “Choreographing Aesthetic Atmospheres”, provides a paradoxical view as opposed to thinking in scientific terms of comfort and ideal thermodynamic criteria such as humidity and temperature[4]. At the same time, from both the aforementioned writing and also in “The Dynamics of Sensual Atmospheres”, Malte doesn’t propose a dismissal of the calculations and technical simulations, rather, a marrying or in some cases a following of the technical to serve the phenomenological[1]. If we begin to understand the power of both schools of thought and allow them to work together, it begins to map out the technical means of achieving the psychosomatic effects. Therefore, in order to effect, we find ways to affect.
Critical Lens

Critical Lens Diagram
The experiments and methodologies outlined in Wagenfeld’s paper “The Dynamics of Sensual Atmospheres” and the various projects on showcase at the RMIT’s Dynamics of Air exhibition explore seemingly contradictory philosophical streams.
On the one end, referencing Ben Anderson’s paper “ Affective Atmospheres”, Atmospheres are understood as a relational phenomena.
“In everyday speech and aesthetic discourse, the word atmosphere is used interchangeably with mood, feeling, ambience, tone and other ways of naming collective affects […]they are the shared ground from which subjective states and their attendant feelings and emotions emerge”.[5]
Although Anderson states that the concept of atmospheres occupies both materiality and ideality, it relies heavily on emotion, perception and sensory relata, characteristics often associated with idealism.[6]

Hybrid Diagram
On the other hand, the same methodologies and experiments referenced above are conceptualized and actualized in an effort to see that which is beyond our senses – efforts that evoke Quentine Meillasoux’s concept of the “arch fossil”[7]. This is an object that indicates “the existence of an ancestral reality or event; one that is anterior to terrestrial life.” In other words, the arche-fossil is, “evidence that exists independently of humans.”[8] Through this line of thought, simply put, Meillasoux looks to disprove the idea that objects only exist through their relation to humans. He removes humans from the center of the diagram, noting that objects and phenomena exist beyond our sensory relata, and relationship to/with them[9]. He uses the terms primary and secondary qualities. Where primary are properties which are inseparable from the object, properties of the thing in-itself, like mass; and secondary is the sensory relationship, the attributes of a thing through a relationship-sense, smell, taste touch etc. As part of this concept Meillasoux proposes that the way we understand something out of our perception, a primary property, is through mathematical terms, which can be meaningfully conceived as properties of the object itself. All aspects of the object can give rise to mathematical thought (formula or digitization) and can be turned into properties of the thing as it is without me (the human)[10].

Air as Vessel Diagram
The experiments undertaken by Wagenfeld and the RMIT exhibitionists, for the most part, utilize digitized (mathematical) means, like lasers, fog machines, artificial intelligence and data gathering to visualize and understand that which is beyond human perception, as it is relates to our understanding of air[2]. However this means is for a sensory end, as these projects bring the unseen, in-itself properties of air into the secondary properties of human sensory relata. Once conceived, the results are understood in metric of human comfort and emotion. Therefore assignment will use a hybrid of the contradictory philosophical streams outlined above to examine case studies of air and computational architecture.
Another important parameter to outline for the purposes of this assignment is that air is understood as a vessel which carries scent, noise, temperature, objects, behavior and light. Each case study will outline computational/mathematical methods used to analyze the aforementioned senses.
By intersecting the unseen with human senses and emotions the concept of atmosphere can begin to overlap with that of air – giving qualitative and quantitative parameters to phenomenological affect. Something which we can begin to utilize in design and architecture.
Case Studies
In order to illustrate the critical lens exposed above, a few example cases have been curated that help illustrate the capabilities of air as a medium.

Olafur Eliasson, The Weather Project, 2003, via olafureliasson.net/archive/artwork/WEK101003/the-weather-project
Like Andersons reflections on how we use the word atmosphere interchangeably with other concepts, Olafur’s installation excels at bringing all of those together through scale, tone, colour and temperature, creating an atmosphere so powerful that affects the way we behave profoundly.

Ned Kahn, Wind Veil, 2000, via nedkahn.com/portfolio/wind-veil
The wind sculptures of Ned Kahn are a beautiful example of the arch fossil, that evidence that exists independently of humans. not only revealing the always present behaviour of the wind around us, but making it the fundamental aspect of his facades.

Andrea Chin, Sensing Nature, 2010, via www.designboom.com/design/tokujin-yoshioka-for-sensing-nature-exhibition/
Used as a performative vessel, air blows through Yoshika’s bird feathers creating temporary landscapes that will never repeat. In a way, air activates matter into mass.

The Fog System, Nakaya’s fog installation, 2011, via www.flickr.com/photos/thefogsystem/albums/72157627168121000
On a bigger scale, Nakaya’s transformations of existing buildings add a new dimension to how they are felt and perceived. Another example of a technological feat: smoke machines are the brushes of ambience.

Jeppe Hein, Smoking Bench, 2002, via www.jeppehein.net/project_id.php?path=works&id=145
The smoking bench really puts air into perspective, in a literal sense. Forced to deal in such a proximity with the smoke, all senses are left changed (sight, smell, warmth and hearing).

Overgaden Ovenvande, Carlsberg Brewery, 2011, via overgadenovenvandet.wordpress.com/2011/11/10/meet-you-at-the-ropes/
Stepping away from the technological sphere, this rope installation brings awareness to the movement in space through senses that are usually disregarded: acceleration, inertia, speed, a sense of hanging, etc. It brings the playfulness of air into evidence.

Tomas Saraceno, On Space Time Foam, 2012, via studiotomassaraceno.org/on-space-time-foam/
Again, technology has allowed for new ways to use air, like in Saraceno’s space time foam, where he is capturing air as an almost structural body. Paradoxically: contained air becomes an unreachable space.
Steve Pike, Arcolony, 2010, via besidemagazine.blogspot.com/2010/10/arcolony-by-steve-pike.html
Contaminant is about how living organisms respond to different types of spaces. Some of these bacteria samples were placed in restaurants, or shops, or hospitals, and transform accordingly to the usage of these spaces. Again, air is the medium for this responsive-architecture, connecting bacteria to architecture function.

Daniel Palacios, Waves, 2010 via www.arch2o.com/waves-daniel-palacios/
Thinking of air as a medium that reveals & carries, Daniel Palacious chose Sound as his tool to visualize it. His installation reacts to those who watch it; When the audience moves around it, they influence the movements of the rope, generating visual and acoustic waves. Depending on how one may act in front of it, and according to the number of observers and their movements, it will pass from a steady line without sound to chaotic shapes of irregular sounds.

Sajad Baharvandi, Wind Catcher, 2021 via unsplash.com/s/photos/wind-catcher
Air is also the medium that drives heat sensations into architecture. In some hard hot environments such as Iran & Egypt, a vernacular architectural element was created to respond to the harsh climate; They’re called Wind Catchers “malqaf’s”; a low tech architectural element works so well that it ended up shaping parts of the architectural grammar in many oriental cities.
Using local construction methods This wind catcher acts as a filter that dispatches air in multiple degrees. It catches winds 15 meters above the ground, and using a funnel, it helps descend the hot air into rooms, creating a cooling breeze that reduces the temperature of the moisturized skin. In some examples a water pond is placed in front to cool the air temperature. [11]

Kamaruzzaman Bin Sopian, Omid Saadatian, “Review of Windcatcher Technologies”,2011, Figure 11 via www.researchgate.net/publication/220004009_Review_of_Windcatcher_Technologies
In an Attempt to understand the windcatcher archetypes, a team of scientists deconstructed the geometries in play; as an example : the number of chambers and the degrees of inclination. [12]

Daniel Prohasky, “Mini Airflow Tunnel Project – Low cost platform of rapid wind analysis for architects” – 2015, via miniwindtunnel.wordpress.com/
Another attempt to understand windflow using technology is Dabiel Prohasky & Rafael Moya’s Mini Airflow Tunnel, which is a miniature wind tunnel incorporating microelectronic sensors and real time sensor data visualization for testing physical prototypes.
This project is made available for everyone to download on their website to aid designers understand the relational dynamic between airflow and porous screens for building facades on a conceptual level.[13]
Conclusion
By intersecting the unseen with human sensory/emotions the concept of atmosphere can begin to overlap with that of air – giving qualitative and quantitative parameters to phenomenological affect.
End Notes
[1] Malte Wagenfeld. “The Dynamics of Sensual Atmospheres” in Dynamics of Air. ed. Jane Burry (Melbourne, Aus: Melbourne Books 2013), 124-125.
[2] Helen Rayment, Malte Wagenfeld, and Jane Burry, “Dynamics of Air” (Melbourne, Aus: RMIT Gallery, 2018), 15,50.
[3] Amir Soltani, “Atmospheric Gestures of Architecture in Cinematic Aided Design Framework” in Alloaesthesia: Senses, Inventions, Worlds (France: Réseau International Ambiances, 2020), 232-237.
[4] Malte Wagenfeld, “Choreographing Æsthetic Atmospheres” in Alloaesthesia: Senses, Inventions, Worlds (France: Réseau International Ambiances, 2020), 174-179.
[5] Ben Anderson, “Affective Atmospheres” Emotion, Space and Society, no.2 (2009): 78.
[6] Quentin Meillassoux “Chapter 1: Ancestrality” in After Finitude (London,GB: Continuum International Publishing Group 2011), 10.
[7] Ibid.14.
[8] Ibid.20.
[9] Ibid.VII.
[10] Malte Wagenfeld. “The Dynamics of Sensual Atmospheres” in Dynamics of Air. ed. Jane Burry (Melbourne, Aus: Melbourne Books 2013), 125.
[11] Kamaruzzaman Bin Sopian, Omid Saadatian, “Review of Windcatcher Technologies”, 2011
[12] A.R.Dehghani-sanija, M.Soltanibc, K.Raahemifard, “A new design of wind tower for passive ventilation in buildings to reduce energy consumption in windy regions – Renewable and Sustainable Energy Reviews, Volume 42, February 2015”, Pages 182-195, 2015.
[13] Mani Williams, Rafael Moya Castro, Daniel Prohasky “A Physical and Numerical Simulation Strategy to Understand the Impact of the Dynamics in Air for the Design of Porous Screens”, 2015.
Bibliography
Anderson, Ben. “Affective Atmospheres” Emotion, Space and Society, no.2 (2009): 77-81.
Rayment, Helen, Malte Wagenfeld, and Jane Burry. Dynamics of Air. RMIT Gallery, 2018.
Meillassoux, Quentin. After Finitude. London,GB: Continuum International Publishing Group, 2011.
Wagenfeld, Malte. “The Dynamics of Sensual Atmospheres” in Dynamics of Air. ed. Jane Burry. 124-139. Melbourne, Aus: Melbourne Books, 2013.
Masson, Damien. In Ambiances, Alloaesthesia: Senses, Inventions, Worlds: 4th International Congress on Ambiances, December 2020, e-Conference. Grenoble: Re?seaux international Ambiances, 2020.
Williams Mani, Moya Castro Rafael, Prohasky Daniel “A Physical and Numerical Simulation Strategy to Understand the Impact of the Dynamics in Air for the Design of Porous Screens”, 2015.
A.R.Dehghani-sanija, M.Soltanibc, K.Raahemifard, “A new design of wind tower for passive ventilation in buildings to reduce energy consumption in windy regions – Renewable and Sustainable Energy Reviews, Volume 42, February 2015”, 2015.
Bin Sopian Kamaruzzaman, Saadatian Omid, “Review of Windcatcher Technologies”, 2011
Credits
AIR is a project of IAAC, Institute for Advanced Architecture of Catalonia developed in the Master In Advanced Computation For Architecture & Design 2021/2022 by students: Zoe Lewis, Sumer Matharu, Joao Silva, Ramdane Mahmoud, and Faculty: Jane Burry
